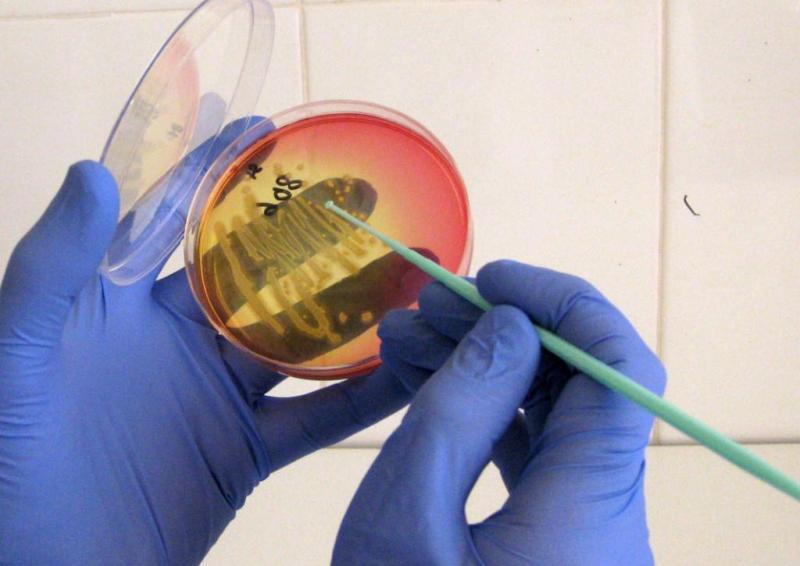

- Типи вірусу папіломи людини
- Чи небезпечний ВПЛ для чоловіків?
- Як передається вірус папіломи у чоловіків
- симптоми папіломовірусу
- Діагностика вірусної інфекції у чоловіків
- Який лікар лікує?
- Лікування і видалення папілом
- препарати
- Деструктивні методи лікування
Серед всіх статевих інфекцій вірус папіломи людини (ВПЛ) займає провідне місце по поширенню і рівню заразність. ВПЛ у чоловіків здатні спровокувати важкі патології сечостатевої системи, аж до розвитку пухлинних процесів пеніса і ануса. 
Папіломи становлять небезпеку для здоров'я чоловіка
Типи вірусу папіломи людини
Розрізняють багато видів папіломовірусною інфекції. Кожен тип має свій номер.
Така класифікація передбачає поділ ВПЛ за рівнем онкогенности і характером новоутворень:
- Поява звичайних бородавок на шкірі - типи 7, 10, 12, 14, 15, 17, з 19 по 24, 26, 27, 29, 57.
- Підошовні папіломи у вигляді мозолів - штами з 1 по 4.
- Низький рівень переростання наростів в ракові пухлини - 6, 11, з 42 по 44, з 53 по 55.
- Штами з високою ймовірністю передраковий стан - з 39 по 43, 61, 62, 64, 67, 69, 70, а також 30.
- Гострі кондиломи доброякісного характеру - 6 і 11.
- Папіломи з високим ризиком розвитку онкогенних пухлин - 35, 31, 33, 58, 66, 45, 39, 66, 51, 16, 52, 18, 59.

Гострі кондиломи - тип ВПЛ 6 і 11
Подібні генотипи папіломовірусною інфекції викликають у людини бородавчасту епідермоплазію, генітальні папіломи, ларингеальний розростання, злоякісні процеси в статевих органах.
Чи небезпечний ВПЛ для чоловіків?
Серед штамів, які несуть велику загрозу, виділяють 18 і 16, а також 32, 33, 35, 52, 51, 58, 66, 69, 59, 39, 45.
Зазначені генотипи викликають ураження пахової зони у чоловіків і можуть спровокувати такі патології:
- проблеми з ерекцією;
- безпліддя;
- імпотенція;
- рак статевого члена і анального отвору.

ВПЛ може викликати проблеми з ерекцією
Найчастіше папіломовірус перебуває в латентній стадії і тривалий час себе не проявляє (поки не дасть збій імунна система). Тому багато чоловіків можуть не здогадуватися про інфекції, але при цьому заражати близьких жінок.
Як передається вірус папіломи у чоловіків
Головний шлях зараження папілломовірусом - інтимні стосунки з інфікованою людиною. Не має значення вид сексу і його безпеку, зараження відбувається зі стовідсотковою ймовірністю. Ризик підхопити небезпечне захворювання зростає з кожною новою партнеркою. ВПЛ передається навіть при поцілунку.

ВПЛ може передаватися навіть під час поцілунку
До другорядних джерел попадання інфекції в організм можна віднести:
- проникнення вірусу через мікротравми на шкірі в громадських басейнах, саунах, на пляжі;
- зараження в косметичному кабінеті, якщо фахівець погано вимив руки та приладдя для процедури після роботи з інфікованим клієнтом;
- погано оброблені медичні інструменти в лікарні.
У людей з міцною захисною системою вірус може загинути або тривалий час перебувати в сплячому стані.
симптоми папіломовірусу
Частіше від чоловіків вражають гострі кондиломи. Вони розвиваються на статевих органах і складках шкіри між ніг. Це невеликі за розмірами приєднання до слизистих оболонок, прикріплені тонкими ніжками. Початкові розміри подібних бородавок від 1 до 5 мм. У процесі свого розвитку вони можуть досягати кілька сантиметрів.
Основними ознаками наявності ВПЛ в організмі є поодинокі нарости або їх скупчення, які розміщуються на голівці пеніса, в області мошонки, на яєчках, під вуздечкою, а іноді і на всьому члені. Як виглядають генітальні папіломи, показано на фото.

Папіломи на голівці статевого члена
Новоутворення в початковій стадії не доставляють людині незручностей, але з часом проявляються неприємними симптомами:
- в результаті тертя об нижню білизну може виникати печіння, свербіж, больовий дискомфорт;
- почервоніння травмованих ділянок, розвиток запалення;
- кровотеча і поява ранок, які тривалий час не загоюються;
- неприємні відчуття при сечовипусканні, випорожненнях;
- біль під час статевого акту.
Важливо!
У чоловіків папіломовірус часто провокує захворювання Боуена - утворення червоних бляшок на статевому члені, які мають чіткі межі і оксамитову шкірку. Головна особливість такого різновиду папіломи - інтенсивне розростання і перетворення в онкологічні ущільнення.
Діагностика вірусної інфекції у чоловіків
Виявлення ВПЛ у чоловіків складається з декількох методів:
- візуальний огляд лікарем статевих органів пацієнта;
- тест на ВПЛ - зішкріб або мазок з пеніса і сечовипускального каналу, який визначає наявність в організмі небезпечного вірусу;
- дослідження біологічного матеріалу на ступінь онкогенности бородавок (біопсія);
- полімеразна ланцюгова реакція.
Мазок з пеніса - один із способів виявити ВПЛ у чоловіків
Так як виявити інфекцію досить складно, найвірогіднішим методом є аналіз ПЦР. Він дозволяє не просто виявити наявність вірусу папіломи, але і визначити його штам і ДНК.
Який лікар лікує?
Щоб точно визначити природу новоутворень в паховій зоні, потрібно знати, до якого лікаря звернутися. Якщо мова йде про розростаннях на пенісі, яєчках, мошонці, під вуздечкою або в складках між ніг, необхідна консультація уролога . У разі поразки папіломами промежини і шкіри навколо анального отвору, як лікувати захворювання, знає проктолог . Головне, не затягувати з візитом до лікаря, інакше можна ускладнити лікування хвороби.

Якщо папіломи з'явилися в області статевого члена, то потрібно звернутися до уролога
Лікування і видалення папілом
Боротьба з генітальними папіломами повинна бути комплексною і включати в себе як деструктивні методи (висічення наростів), так і медикаментозну терапію.
препарати
Для досягнення максимального терапевтичного ефекту лікарі призначають комбіноване лікування, яке має на увазі прийом декількох груп препаратів одночасно.
- Противірусні ліки пригнічують папіломовірусною інфекцію і переводять захворювання в стадію ремісії. Найбільш ефективні препарати з цієї групи - ін'єкції Интрон А, свічки, мазь і таблетки Віферон, ректальні і вагінальні супозиторії Генферон.
- Імуностимулятори. Медикаменти - кемантан, Изопринозин, Гепон - активують захисний бар'єр організму, гальмують поділ клітин вірусу і знижують ризик рецидивів.
- Деструктивні ліки і цитотоксичні засоби. За допомогою хімічних речовин - Солкодерм, Подофіллін, Подофиллотоксин - припікають папіломи і провокують їх відмирання в короткі терміни.

Інтрон А - ефективний противірусний засіб
Всі препарати повинен призначати тільки фахівець після ретельного обстеження. Це допоможе підібрати найкращі сркдсва і домогтися високого терапевтичного ефекту.
Деструктивні методи лікування
Знаючи, чим небезпечні папіломи, потрібно розуміти, що залишати такі утворення на шкірі не можна. Для видалення генітальних наростів існує кілька ефективних способів.
- Лазерне висічення. За допомогою лазера видаляється бородавка, а місце зрізу «запаюється», що дає можливість уникнути кровотеч, запалень і утворення рубців. Процедура повністю безболісна і не вимагає анестезії.
- Радіохвильова хірургія. Папіломи зрізаються радіохвильовим скальпелем, який акуратно впливає на тканини, не зачіпаючи здорові ділянки. Маніпуляція не залишає рубців, добре переноситься пацієнтами.
- Електрокоагуляція. Генітальні бородавки видаляються за допомогою їх припікання струмом високої частоти, в результаті чого розростання підсихають і відпадають. Процедура виключає запальні процеси і рубцювання тканин.
- Припікання рідким азотом - кріодеструкція - обробка уражених місць азотом низьких температур. При такому впливі папіломи засихають і відмирають.
- Хірургічне висічення - зріз бородавки здійснюється скальпелем, потім ранка обробляється спеціальним розчином і туго перев'язується. Маніпуляція проводитися під місцевим наркозом, має тривалий період відновлення пошкоджених тканин.
Після видалення генітальних папілом чоловікам призначається противірусна і іммуномоделірующіе терапія. Такий підхід сприяє пригніченню вірусу, і стимулюють імунні сили організму.
Вірус папіломи людини - інфекційне захворювання, які переважно передається статевим шляхом. Його небезпека полягає у високій імовірності перетворення доброякісних наростів в онкогенні пухлини. Щоб запобігти важкі ускладнення, важливо вчасно звертатися до фахівця при виявленні підозрілих утворень в паху і не займатися самолікуванням. В іншому випадку можна спровокувати негативні наслідки.
інфекції
Чи небезпечний ВПЛ для чоловіків?Який лікар лікує?













